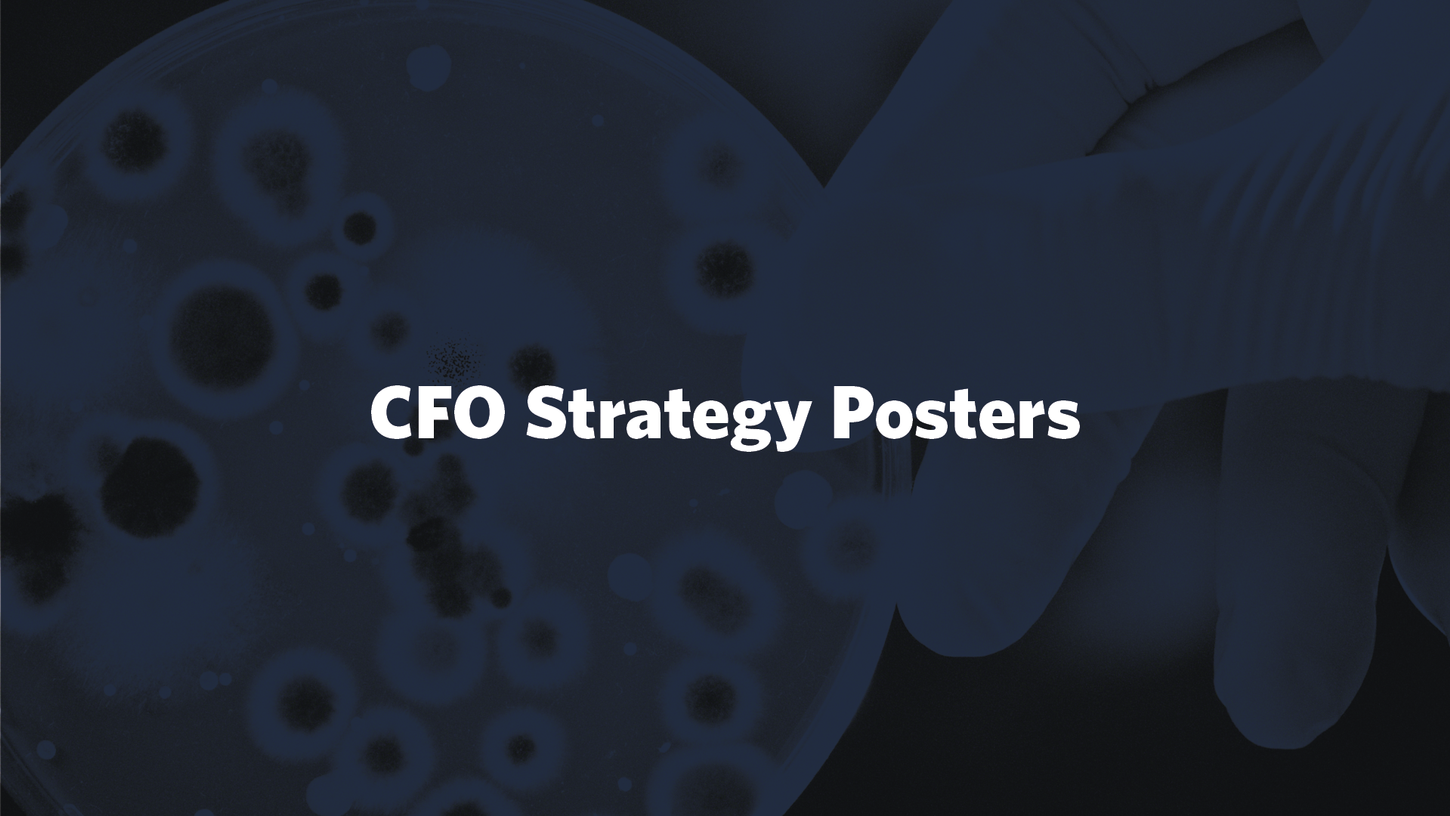

Jobtitel: Senior Graphic Designer
Department: Corporate Branding
As the Senior Graphic Designer at Chr. Hansen I have been responsible for the conceptualization and design processes of visual communication in Corporate Branding, and also responsibel for the build up of a scalable brand setup for the organization for developing and guarding Chr. Hansen’s global brand experience - conveyed across all platforms. This includes for instance the creative development, design of all layouts and publishing setup for an international poster concept for all of Chr. Hansen and it’s different departments in different countries, that evolved and unified the Chr. Hansen brand experience.
As part of Chr. Hansen’s ambitous sustainability goals towards the 2050 European unioin climate goals, I also created the creative concept for the large scale campaign called Think Climate, afterwhich I executed the campaign, including logo design, a selected range of large scale posters and a wide range of other medias, including SOME formats for publication across different online platforms.